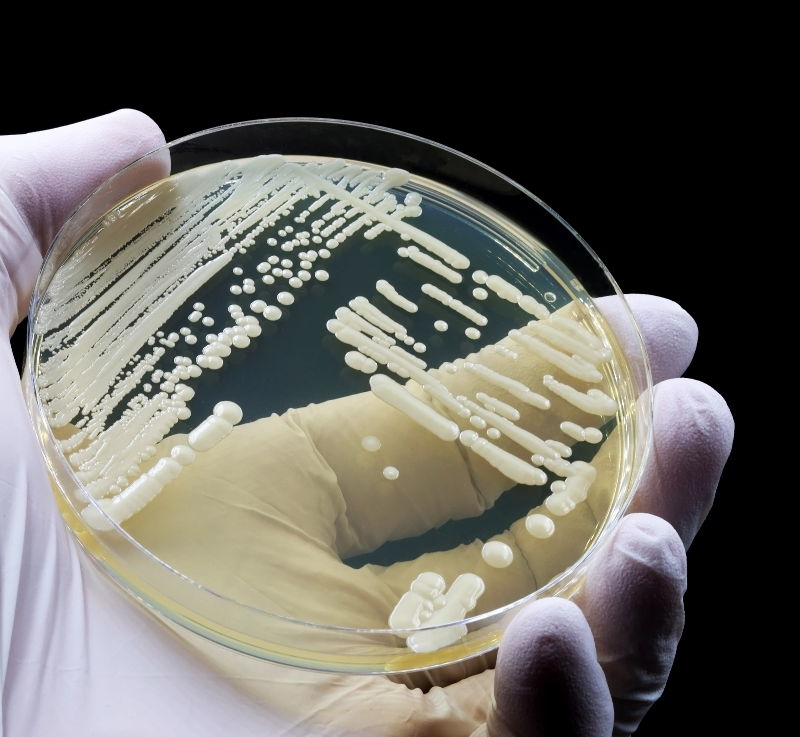

Alle Unternehmensstrukturen sind auf unterschiedlichen Ebenen am Arzneimittelherstellungsprozess beteiligt...
Informationen für fachkreise
Die in diesem Abschnitt enthaltenen Informationen sind ausschließlich für die Verwendung durch medizinisches Fachpersonal bestimmt.